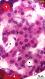

Please use this identifier to cite or link to this item:
https://hdl.handle.net/2445/223675| Title: | Histological organisation of the pancreas in rats |
| Other Titles: | Organització histològica del pàncrees de la rata |
| Author: | Pérez Clausell, Jeús Universitat de Barcelona. Departament de Biologia Cel·lular, Fisiologia i Immunologia |
| Keywords: | Tub digestiu Duodè Pàncrees Illots de Langerhans Histologia Rates (Animals de laboratori) |
| Issue Date: | 2025 |
| Citation: | Cite as: Pérez-Clausell J (2025) << Title>>. Universitat de Barcelona. Departament de Biologia Cel·lular, Fisiologia i Immunologia. Dipòsit digital UB [consulted on <<date>>] https://hdl.handle.net/2445/?????? |
| Abstract: | [ENG] A collection of micrographs of the pancreas in rats. General views and details of the exocrine acini, endocrine islets, secretory ducts, arteries, and veins are shown. Paraffin sections were stained with hæmatoxylin-eosin or van Gieson's trichrome, while epoxy semi-thin sections (2 µm thick) were stained with toluidine blue.
This collection complements the micrographs published by Dr Elena Sagristà i Mateo → https://diposit.ub.edu/dspace/handle/2445/60217 ← See also: → https://diposit.ub.edu/dspace/browse?type=author&value=Sagrist%C3%A0+i+Mateo%2C+Elena ← [CAT] Col·lecció de micrografies que mostren l'organització histològica del pàncrees de la rata i la relació amb el duodè. S’hi observa tant l'aspecte general del pàncrees com detalls dels àcins exocrins, els illots endocrins (de Langerhans), els conductes secretors, artèries i venes. S'han utilitzat talls de parafina tenyits amb hematoxilina-eosina o el tricròmic de van Gieson, així com talls semifins de 2 µm tenyits amb blau de toluïdina. Aquesta col·lecció complementa les micrografies publicades per la Dra. Elena Sagristà i Mateo → https://diposit.ub.edu/dspace/handle/2445/60217 ← See also: → https://diposit.ub.edu/dspace/browse?type=author&value=Sagrist%C3%A0+i+Mateo%2C+Elena ← |
| URI: | https://hdl.handle.net/2445/223675 |
| Appears in Collections: | OMADO (Objectes i MAterials DOcents) |
Files in This Item:
| File | Description | Size | Format | |
|---|---|---|---|---|
| P_O_duodenum_HEosin_4x_47_LETTERS.jpg | Duodenum and adjoining pancreas in a rat. The pancreatic acini are darkly stained and form discrete masses – lobules – embedded in the mesenterium (mes), which is lightly stained and joins the duodenal wall. Intralobular septa of loose connective tissue – virtually unstained – separate these acinar masses, and blood vessels – arteries (ar) and veins (ve) – lie within them. The duodenal wall exhibits the typical layers: mucosa, submucosa (sub), and muscularis externa (me). The mucosa projects into the lumen, forming villi (black arrowheads). They are lined by a single-layered epithelium and enclose a loose connective tissue: the lamina propria (lp) which is palely stained. The epithelium also invaginates into the mucosa, forming crypts. A thin muscularis mucosæ (mm) constitutes the deepest border of the mucosa. Beneath this lies the submucosa (sub), a moderately stained connective tissue layer, and then a compact muscularis externa (me) which stains heavily. Paraffin section, hæmatoxylin-eosin stain. | 1.34 MB | JPEG |  View/Open |
| P_O_duodenum_HEosin_4x_47.jpg | Duodenum and adjoining pancreas in a rat. No labelling. | 1.3 MB | JPEG |  View/Open |
| P_O_pancreas_HEosin_4X_03_06_collage_LETTERS.jpg | Duodenal lobe of the rat pancreas (collage of micrographs allowing moderate zoom). Pancreatic acini are darkly stained and lie in the palely stained mesenterium, which is wrapped in a thin serosa (ser). Faintly stained septa of connective tissue separate the acinar lobules. These septa accommodate large and small branches of arteries (ar) and veins (ve), which also reach the duodenal wall. In this longitudinal section of the duodenum, only its deepest layers are seen: the crypts and a thin muscularis mucosæ (mm), supported by a moderately stained submucosa (sub), followed by another smooth muscle layer – muscularis externa –. This layer can be divided into inner and outer sublayers, which are barely noticeable even when zooming in. Paraffin section, hæmatoxylin-eosin stain. | 1.66 MB | JPEG |  View/Open |
| P_O_pancreas_HEosin_4X_03_06_collage.jpg | Duodenal lobe of the rat pancreas (collage of micrographs). No labelling. | 1.6 MB | JPEG |  View/Open |
| P_O_pancreas_HEosin_20X_07_10_collageB_LETTERS.jpg | Duodenal wall and pancreatic lobules (collage of micrographs allowing detailed zoom). In the duodenum, villi are seen projecting from the wall and lined by a simple columnar epithelium (ep, bidirectional white arrows). Goblet cells (Go) can be seen interspersed between the absorptive cells, which are stained darker. Invaginations of the epithelium form crypts, surrounded by a pale lamina propria (lp). A thin layer of smooth muscle cells – the muscularis mucosæ (mm) – marks the inner border of the mucosa. A denser connective tissue is located underneath, forming the submucosa (sub). The muscularis externa (me) can be seen arranged into two layers: the inner or circular (ic), and the outer or longitudinal (ol). A virtually unstained mesenterium (mes) supports the pancreatic lobules and attaches them to the duodenum. Fibroblasts (fi) and delicate collagen fibres (black arrowheads) are found there. Intralobular septa (empty arrowheads) – also unstained – separate the acinar masses. In these, each acinus appears as a ring stained blue or purple with a core stained red. Acinar cell nuclei (N) are located in that peripheral ring, and are stained dark blue or purple. Arterioles (ar) and venules (v) of various sizes lie in the septa and inside the acinar masses. Paraffin section, hæmatoxylin-eosin stain. | 1.3 MB | JPEG |  View/Open |
| P_O_pancreas_HEosin_20X_07_10_collageB.jpg | Duodenal wall and pancreatic lobules (collage of micrographs). No labelling. | 1.18 MB | JPEG |  View/Open |
| P_O_duodenum_HEosin_20x_50_LETTERS.jpg | Pancreatic acini and septa in a rat. Each acinus consists of a core, which stains vivid red with eosin (asterisk), and a bluish outer ring in which round or oval nuclei (N) stain darkly. Zooming into the figure reveals paler round spots in the core of the acini (black arrows): the secretory granules. Intralobular septa (empty arrowheads) separate the acinar groups. Blood vessels of various sizes (v) lie in the septa and among the acini. A longitudinal section of what appears to be a blood vessel is seen in a septum (star). An intercalated secretory duct (id) is observed between the acini. Paraffin section, hæmatoxylin-eosin stain. | 851.26 kB | JPEG |  View/Open |
| P_O_duodenum_HEosin_20x_50.jpg | Pancreatic acini and septa in a rat. No labelling. | 802.6 kB | JPEG |  View/Open |
| P_O_pancreas_HEosin_50x_34_acini_LETTERS.jpg | Pancreatic acini in a rat. Each acinus consists of a round group of secretory cells with nuclei (N) that stain dark blue. They lie at the basal portion of the cell (i.e., at the periphery of the acinus), where the cytoplasm also stains blue. The apical portion of the cells – the core of the acinus (asterisk) – appears so intensely red that secretory granules cannot be distinguished. In the loose connective tissue enveloping the acini, fibroblasts (fi) can be observed. Paraffin section, hæmatoxylin-eosin stain. | 492.67 kB | JPEG |  View/Open |
| P_O_pancreas_HEosin_50x_34_acini.jpg | Pancreatic acini in a rat. No labelling. | 452.1 kB | JPEG |  View/Open |
| P_O_pancreas_HEosin_100x_22_acinus_LETTERS.jpg | Detail of pancreatic acini in a rat. Cytoplasm in the periphery stains blue or purple, and the nuclei (N) lie there, exhibiting some chromatin clumps. The apical cytoplasm, in the core of the acini, stains vivid red with some unevenness indicative of secretory granules. The cells open to a narrow lumen (L) lined by centroacinar cells, whose nuclei (ce) are seen in longitudinal section. In the connective tissue surrounding the acini, fibroblasts (fi) can be observed. Paraffin section, hæmatoxylin-eosin stain. | 378.13 kB | JPEG |  View/Open |
| P_O_pancreas_HEosin_100x_22_acinus.jpg | Detail of pancreatic acini in a rat. No labelling. | 345.14 kB | JPEG |  View/Open |
| P_O_pancreas_HEosin_20X_12_duct_LETTERS.jpg | Secretory duct and vessels in the pancreatic septa of a rat. In the muscular wall of the arteriole (ar) – stained pink – and in that of the larger venule (v), the epithelial cell nuclei cannot be distinguished at this magnification. In contrast, in the secretory duct (d), round or oval cell nuclei are readily spotted within the wall (black arrows), corresponding to a simple cuboidal epithelium. The lumen of the duct contains secretion products that stain bright pink. Ducts and vessels lie in a matrix of loose connective tissue with delicate collagen fibres (black arrowheads) and fibroblasts (fi). Bordered by the connective tissue, masses of acini are seen, each showing a red core (asterisk) encircled by a blue ring of nuclei. Paraffin section, hæmatoxylin-eosin stain. | 362.72 kB | JPEG |  View/Open |
| P_O_pancreas_HEosin_20X_12_duct.jpg | Secretory duct and vessels in the pancreatic septa of a rat. No labelling. | 343.99 kB | JPEG |  View/Open |
| P_O_pancreas_HEosin_50X_20_duct_LETTERS.jpg | Secretory duct and small blood vessels in the rat pancreas. The lumen of the duct (d) is filled with secretion – stained pink –, and is lined with short cells of the cuboidal type, which contain round or oval nuclei (small arrows). The duct lies in the vicinity of an arteriole (ar), a venule (ve), and pancreatic acini with a red core (asterisk) and a dark blue ring around it. All these structures lie in a loose connective tissue containing thin collagen fibres (col, and black arrowheads) stained light pink, and fibroblasts (fi). Paraffin section, hæmatoxylin-eosin stain. c, capillary. | 479.26 kB | JPEG |  View/Open |
| P_O_pancreas_HEosin_50X_20_duct.jpg | Secretory duct and small blood vessels in the rat pancreas. No labelling. | 453.4 kB | JPEG |  View/Open |
| P_O_pancreas_HEosin_50x_30_31_duct_collage_LETTERS.jpg | Acini and intercalated duct in the rat pancreas (collage of micrographs allowing detailed zoom). Acini have a dense red core (asterisks) with a diffuse granular appearance, surrounded by cell nuclei (Nˬa) and cytoplasm, both stained blue and located in the periphery. In the acini, centroacinar cells (ce) form an intercalated duct (white arrows) which joins the transverse section of a small duct (dˬt) that contains oval nuclei in its wall (Nˬt). This duct is joined by a longitudinal section of a smaller duct extending from the upper right corner of the figure, with nuclei in its wall sectioned longitudinally (Nˬl). The lumen of these ducts is filled with secretion (stars) that stains light pink. Paraffin section, hæmatoxylin-eosin stain. | 402.92 kB | JPEG |  View/Open |
| P_O_pancreas_HEosin_50x_30_31_duct_collage.jpg | Acini and intercalated duct in the rat pancreas (collage of micrographs). No labelling. | 363.02 kB | JPEG |  View/Open |
| P_O_pancreas_HEosin_100x_21_duct_LETTERS.jpg | Small secretory duct next to a pancreatic acinus in a rat. The duct is filled with secretion that stains pink (star), and is lined with a single layer of short – cuboidal – epithelial cells, whose cytoplasm stains vivid pink and contain round or oval nuclei (Nˬd) stained dark purple. The duct is surrounded by coarse collagen fibres (empty arrowheads) and lies next to a venule (ve) and several capillaries (c). In neighbouring acini, nuclei (Nˬa) are large, heavily stained, and located in the periphery, while the core stains dark red. The lumen of the acini is tentatively labelled. Paraffin section, hæmatoxylin-eosin stain. | 366.7 kB | JPEG |  View/Open |
| P_O_pancreas_HEosin_100x_21_duct.jpg | Small secretory duct next to a pancreatic acinus in a rat. No labelling. | 338.13 kB | JPEG |  View/Open |
| P_O_pancreas_HEosin_50X_32_33_collage_LETTERS.jpg | Large secretory duct in the rat pancreas (collage of micrographs allowing detailed zoom). The duct is lined by a single-layered epithelium made of short cells with a round nucleus (Nˬd) that fills most of the cell. This simple cuboidal epithelium is surrounded by connective tissue that contains a thick layer of collagen fibres (col) densely packed and stained pink. Capillaries (c) can be seen in this compact wall and around it. This duct is surrounded by loose connective tissue that is virtually unstained except for some thin collagen fibres (empty arrowheads), blood vessels (v), and scattered cells. Pancreatic acini show the characteristic red core (asterisk) surrounded by dark blue cell nuclei in the periphery. Paraffin section, hæmatoxylin-eosin stain. Star, secretion products in the duct lumen. | 448.4 kB | JPEG |  View/Open |
| P_O_pancreas_HEosin_50X_32_33_collage.jpg | Large secretory duct in the rat pancreas (collage of micrographs). No labelling. | 419.1 kB | JPEG |  View/Open |
| P_O_pancreas_HEosin_100x_23_24_collage_large_duct_LETTERS.jpg | Detail of a large secretory duct in the rat pancreas (collage of micrographs allowing moderate zoom). The duct is lined with a single-layered epithelium containing round or elongated cell nuclei (Nˬd). Secretory products in the duct form aggregates (sec) that stain bright pink and can be seen as a pink band over the epithelium at the top and right side of the duct. Beneath the epithelium lies a compact band (bidirectional white arrows) of connective tissue with thick collagen fibres (empty arrowheads), scattered cells, and blood vessels (v), including capillaries (c). Paraffin section, hæmatoxylin-eosin stain. | 406.43 kB | JPEG |  View/Open |
| P_O_pancreas_HEosin_100x_23_24_collage_large_duct.jpg | Detail of a large secretory duct in the rat pancreas (collage of micrographs). No labelling. | 369.28 kB | JPEG |  View/Open |
| P_O_pancreas_HEosin_20X_13_islet_LETTERS.jpg | Islet of Langerhans and pancreatic lobules in a rat. Pancreatic acini are heavily stained: cell nuclei and the basal cytoplasm are stained dark blue or purple, defining an outer ring in the acinus while the core (asterisks) stains dark red. They are grouped in triangle-shaped lobules separated by unstained septa of connective tissue (empty arrowheads). In contrast, islets (dashed outline) appear as round masses of moderately stained cells, with a pink cytoplasm and bluish nuclei. Paraffin section, hæmatoxylin-eosin stain. d, secretory duct; fi, fibroblast; intercalated, intercalated duct within a lobule; v, venule. | 684.2 kB | JPEG |  View/Open |
| P_O_pancreas_HEosin_20X_13_islet.jpg | Islet of Langerhans and pancreatic lobules in a rat. No labelling. | 629.42 kB | JPEG |  View/Open |
| P_O_pancreas_HEosin_20X_14_duct_LETTERS.jpg | Pancreatic islet, acini and ducts in a rat. The islet (dashed profile) contains cells with a moderately stained pink cytoplasm and blue nuclei. It is surrounded by acini with heavily stained cells: bright red in the apical part (asterisks) and dark blue basally, where the nuclei and parts of the cytoplasm are located. An intercalated duct (d, black arrows) emerges from some acini, possibly joining an interlobular duct (inter) in adjacent histological sections. The epithelial layer (ep) in the large duct is enveloped by a dense layer of connective tissue (ct), which is moderately stained. The septa between the acini are almost unstained and accommodate blood vessels: arterioles (ar) and venules (v). The profile on the left (empty arrowheads) probably corresponds to a longitudinal section of a venule or a capillary. Paraffin section, hæmatoxylin-eosin stain. | 620.81 kB | JPEG |  View/Open |
| P_O_pancreas_HEosin_20X_14_duct.jpg | Pancreatic islet, acini and ducts in a rat. No labelling. | 577.24 kB | JPEG |  View/Open |
| P_O_pancreas_HEosin_50x_27_islet_LETTERS.jpg | Pancreatic islet in a rat. Endocrine cells in the islets exhibit a bluish nucleus (N) and a pink cytoplasm, both moderately stained. Some regions in the islet are faintly stained (stars). Capillaries (c) can be seen within the islet and around it. The islet is surrounded by exocrine acini, which have a bright red apical cytoplasm (asterisks) and dark blue nuclei located peripherally. Paraffin section, hæmatoxylin-eosin stain. | 501.42 kB | JPEG |  View/Open |
| P_O_pancreas_HEosin_50x_27_islet.jpg | Pancreatic islet in a rat. No labelling. | 487.44 kB | JPEG |  View/Open |
| P_O_pancreas_HEosin_100x_25_26_collage_islet_LETTERS.jpg | Detail of a pancreatic islet in a rat (collage of micrographs allowing detailed zoom). The nuclei of the endocrine cells (N) are moderately stained, showing finely granulated chromatin and some larger clumps. The cytoplasm stains pink with a vacuolated appearance, suggestive of secretory granules. Some paler granular regions (stars) are present. Pancreatic acini (asterisks) are seen bordering the islet. Paraffin section, hæmatoxylin-eosin stain. c, capillary. | 368.8 kB | JPEG | View/Open |
| P_O_pancreas_HEosin_100x_25_26_collage_islet.jpg | Detail of a pancreatic islet in a rat (collage of micrographs). No labelling. | 355.99 kB | JPEG |  View/Open |
| P_O_duodenum_vanGieson_4x_01_02_collage2_LETTERS.jpg | Duodenum and the adjacent pancreatic lobe in a rat (collage of micrographs allowing moderate zoom). This longitudinal section of the duodenum shows numerous villi (black arrowheads) projecting into the lumen, while epithelial invaginations into the mucosa give rise to crypts. The lamina propria (lp) – within the villi and around the crypts – is lightly stained, and a thin muscularis mucosæ (mm) delineates the deepest border of the mucosa. The submucosa (sub) is brightly stained with acid fuchsin, in contrast to the muscularis externa (me), which stains brown. A portion of the duodenal lobe of the pancreas is shown underlying the intestinal wall. Pancreatic elements are embedded in a delicate, laminar mesenterium, which is virtually unstained and enveloped by a thin serosa (ser). Pancreatic acini are intensely stained and grouped in loose masses or lobules separated by narrow to wider septa of loose connective tissue, which are poorly stained. Arteries (ar) and veins (ve) lie in these septa and extend into the intestinal wall. Paraffin section, van Gieson trichrome. v, blood vessel. | 1.16 MB | JPEG |  View/Open |
| P_O_duodenum_vanGieson_4x_01_02_collage.jpg | Duodenum and the adjacent pancreatic lobe in a rat (collage of micrographs). No labelling. | 1.01 MB | JPEG |  View/Open |
| P_O_pancreas_vGieson_20x_36_38_collage_LETTERS.jpg | Deeper layers in the duodenum and adjoining pancreas in a rat (collage of micrographs allowing detailed zoom). The deeper portions of the intestinal mucosa are shown: crypts lined with a dark epithelium (ep) are surrounded by a barely stained lamina propria (lp), and the inferior border is marked by a thin muscularis mucosæ (mm). The submucosa (sub) stains heavily with acid fuchsin due to the density of collagen fibres. Beneath it lies the muscularis externa divided into an inner – circular – layer (ic) and an outer – longitudinal – layer (ol), both showing dark nuclei contrasting with the pale brown cytoplasm. A virtually unstained mesenterium (mes) attaches the pancreas to the intestinal wall and encompasses the pancreatic lobules, forming septa (empty arrowheads) of loose connective tissue containing delicate collagen fibres stained pale pink (black arrowheads) and fibroblasts (fi). Pancreatic acini exhibit a pale brown core (white asterisks) surrounded by a dark ring containing the cell nuclei (N), which stain dark brown or purple. Paraffin section, van Gieson trichrome. c, capillary; v, blood vessel. | 1.06 MB | JPEG |  View/Open |
| P_O_pancreas_vGieson_20x_36_38_collage.jpg | Deeper layers in the duodenum and adjoining pancreas in a rat (collage of micrographs). No labelling. | 986.66 kB | JPEG |  View/Open |
| P_O_pancreas_vGieson_20x_35_duct_LETTERS.jpg | Pancreatic acini and connective tissue septa in the rat pancreas. Pancreatic acini appear as round cell groups with dark brown nuclei (N) and cytoplasm in the periphery, and a central region (asterisks), where the cytoplasm stains yellowish or pale brown. Septa of loose connective tissue (empty arrowheads), which are poorly stained, separate the acini into triangle-shaped lobules. The connective tissue also accommodates arteries (ar), veins (ve), and secretory ducts (d), all of which are surrounded by thicker collagen fibres stained bright pink (black arrowheads). Paraffin section, van Gieson trichrome. | 738.55 kB | JPEG |  View/Open |
| P_O_pancreas_vGieson_20x_35_duct.jpg | Pancreatic acini and connective tissue septa in the rat pancreas. No labelling. | 703.79 kB | JPEG |  View/Open |
| P_O_duod_pancreas_duct_vanGieson_50x_16_LETTERS.jpg | Pancreatic acini in a rat. Acini appear as rounded, compact cellular masses in which the narrow central lumen is not noticeable. Cytoplasm in the periphery of the acini stains purple and extends around the nucleus. Nuclei (N) are darkly stained and exhibit chromatin clumps (black arrowheads). Some cells appear to be binucleated (2x), as previously reported (Morgan et al., 1986). In contrast to the periphery, the core of the acini contains regions of the cytoplasm stained light brown, and – when the figure is enlarged – secretory granules appear to be faintly outlined. Paraffin section, van Gieson trichrome. Empty arrowheads, connective tissue septa; fi, fibroblasts. →Morgan RGH, Schaeffer BK, Longnecker DS (1986) Size and number of nuclei differ in normal and neoplastic acinar cells from rat pancreas. Pancreas 1(1): 37-43. | 620.94 kB | JPEG |  View/Open |
| P_O_duod_pancreas_duct_vanGieson_50x_16.jpg | Pancreatic acini in a rat. No labelling. | 587.13 kB | JPEG |  View/Open |
| P_O_pancreas_vGieson_100x_53_acini_LETTERS.jpg | Detail of pancreatic acini in a rat. At high magnification, the narrow lumen in an acinus is faintly noticeable (black arrowheads). The cytoplasm in the central zone of the acini stains pale yellow or brown and has a vacuolated appearance possibly revealing the presence of secretory granules. In the periphery of the acini, the cytoplasm stains pale to moderate purple in a wide zone that also contains the nuclei. The nuclei are round and show loose chromatin with darker chromatin clumps (empty arrowheads). The core of the acini contains centroacinar cells, whose nuclei (ce) are elongated. Paraffin section, van Gieson trichrome. en, endothelial cell of a capillary. | 444.51 kB | JPEG |  View/Open |
| P_O_pancreas_vGieson_100x_53_acini.jpg | Detail of pancreatic acini in a rat. No labelling. | 422.28 kB | JPEG |  View/Open |
| P_O_duod_pancreas_duct_vanGieson_50x_14_LETTERS.jpg | Blood vessels in the rat pancreas. In the poorly stained interlobular septa lie blood vessels. Arterioles (ar) are lined with endothelial cells exhibiting flattened nuclei (en). Beneath the endothelium lies a layer of smooth muscle cells with light brown cytoplasm and elongated nuclei (sm) stained light purple. The arteriole is enveloped by a thin layer of collagen fibres (col) stained bright pink. Venules have thinner walls: only the endothelial cell nuclei (en) and a few collagen fibres stained pink can be observed. Capillaries (c) are much narrower than venules and also exhibit a thin wall. The septa are virtually unstained except for a few collagen fibres (empty arrowheads). These septa are in contact with pancreatic acini, which show a pale brown core (asterisks) and a densely stained periphery containing dark nuclei (black arrowheads). Paraffin section, van Gieson trichrome. | 556.01 kB | JPEG |  View/Open |
| P_O_duod_pancreas_duct_vanGieson_50x_14.jpg | Blood vessels in the rat pancreas. No labelling. | 502.41 kB | JPEG |  View/Open |
| P_O_doud_pancreas_duct_vanGieson_20x_11_LETTERS.jpg | Pancreatic lobule and duct in a rat. Acini are separated by thin septa (empty arrowheads) of loose connective tissue that are poorly stained. Septa contain thin collagen fibres (black arrowheads) stained pink and fibroblasts (fi). They also accommodate blood vessels: arterioles (ar) and venules (ve). The acini exhibit dark nuclei (N) in the periphery and a lightly stained core (asterisks), which appears granulated (gr). Secretory ducts collect the secretion from the acini. A longitudinal section of an intercalated duct (dˬl) is seen exiting the acini (curved arrow) and joining a larger duct (d). Cells lining the intercalated duct show moderately stained, purple nuclei. The main duct is surrounded by collagen fibres which stain vivid pink. Both ducts contain secretion stained pale brown or orange. Paraffin section, van Gieson trichrome. v, capillary or venule in longitudinal section. | 756.02 kB | JPEG |  View/Open |
| P_O_doud_pancreas_duct_vanGieson_20x_11.jpg | Pancreatic lobule and duct in a rat. No labelling. | 705.67 kB | JPEG |  View/Open |
| P_O_duod_pancreas_duct_vanGieson_50x_18_LETTERS.jpg | Pancreatic acini, vessels, and secretory duct in a rat. Acini show a light brown core (asterisk) in which secretory granules are faintly noticeable (gr). The periphery of the acini stains pale to moderate purple, and includes the cell nuclei (N, indicated by white arrowheads). A transverse section of a small secretory duct (d) is seen: cells in the wall are short – cuboidal – with a round or oval nucleus (N). Thin, pink collagen fibres (black arrowheads) surround the duct. In the unstained septa separating the acini, blood vessels are located. They are lined with a thin endothelium with flattened cell nuclei (en). The arterioles (ar) have a thin muscular wall stained light brown, while the wall of the venule (ve) is much thinner. Paraffin section, van Gieson trichrome. c, capillary. | 511.27 kB | JPEG |  View/Open |
| P_O_duod_pancreas_duct_vanGieson_50x_18.jpg | Pancreatic acini, vessels, and secretory duct in a rat. No labelling. | 469.73 kB | JPEG |  View/Open |
| P_O_duod_pancreas_duct_vanGieson_50x_13_LETTERS.jpg | Secretory ducts in the rat pancreas. Acini appear as round cellular aggregates with dark nuclei located in the periphery (white arrowheads) and a light brown cytoplasm in the core (asterisks). An intercalated secretory duct is seen exiting the acini (curved arrow) and joining a thin secretory duct sectioned longitudinally (dˬl), which joins a larger duct cut transversally (dˬt). The ducts are lined with a thin epithelium of short cells (cuboidal) with elongated or round nuclei (N). This epithelium is surrounded by thin collagen fibres (black arrowheads), which stain pink and are more abundant around the larger duct. Paraffin section, van Gieson trichrome. c, capillary. | 621.75 kB | JPEG |  View/Open |
| P_O_duod_pancreas_duct_vanGieson_50x_13.jpg | Secretory ducts in the rat pancreas. No labelling. | 575.59 kB | JPEG |  View/Open |
| P_O_pancreas_vGieson_50x_45_duct_LETTERS.jpg | Large secretory duct in the rat pancreas. The duct is lined with a thin epithelium with elongated nuclei (Nˬd) stained dark purple. In the lumen, pancreatic secretion precipitated during fixation has formed an irregular mass that appears yellowish due to the staining (star). A thick layer of connective tissue with abundant collagen fibres (col, and bidirectional arrows) surrounds the epithelium. Capillaries (c) can be seen in the wall and in the loose connective tissue, in which pink, delicate collagen fibres (empty arrowheads) are scattered. On the right, a tangential section of a small duct (black arrowheads) appears to be joining the main duct. Paraffin section, van Gieson trichrome. Asterisk, pancreatic acinus; v, capillary in longitudinal section. | 523.17 kB | JPEG |  View/Open |
| P_O_pancreas_vGieson_50x_45_duct.jpg | Large secretory duct in the rat pancreas. No labelling. | 472.85 kB | JPEG |  View/Open |
| P_O_pancreas_vGieson_20x_39_islet_LETTERS.jpg | Pancreatic acini and a Langerhans islet in a rat. Pancreatic acini predominate over the islet. Acini are composed of a dense core which is palely stained (asterisks), and is surrounded by a ring corresponding to the cell nuclei (N) and parts of the cytoplasm, both darkly stained. Intercalated secretory ducts (id) and intralobular ducts (d) are seen in the acinar groups – lobules –. The islet (dashed outline) appears as a spongy, round mass of moderately stained cells with no ducts, and surrounded by vividly stained acini. Cell masses are separated by thin septa of loose connective tissue containing fibroblasts (fi), thin collagen fibres (black arrowheads) and blood vessels (v). Paraffin section, van Gieson trichrome. c, capillary. | 701.1 kB | JPEG |  View/Open |
| P_O_pancreas_vGieson_20x_39_islet.jpg | Pancreatic acini and a Langerhans islet in a rat. No labelling. | 657.74 kB | JPEG |  View/Open |
| P_O_pancreas_vGieson_50x_41_islet_LETTERS.jpg | Pancreatic islet and acini in a rat. The islet appears as a round mass of cells that contain a round nucleus (Nˬi) and a paler, pink cytoplasm, which appears to be vacuolated. The islet is bordered by vividly stained acini, which have a brownish or orange core (asterisks) and a darker periphery containing the cell nuclei (Nˬa). The islet is also limited by loose connective tissue – poorly stained – that contains fibroblasts (fi), delicate collagen fibres (black arrowheads), and blood vessels such as capillaries (c). Paraffin section, van Gieson trichrome. | 534.73 kB | JPEG |  View/Open |
| P_O_pancreas_vGieson_50x_41_islet.jpg | Pancreatic islet and acini in a rat. No labelling. | 534.73 kB | JPEG |  View/Open |
| P_O_pancreas_vGieson_100x_50_acini_islet_LETTER.jpg | Endocrine cells in the pancreatic islets, and acinar cells. Cells in the islet show a large, round nucleus (Nˬi) with a fine granular appearance, except for a few, larger chromatin clumps. The cytoplasm stains faintly, but a granular pattern can be recognised (dashed outline), including large granules (stars) and smaller ones. In the acini, cell nuclei have a similar appearance, and the central cytoplasm (asterisk) stains vividly brown or orange, also exhibiting a faint granular appearance. Rat, paraffin section, van Gieson trichrome. L, lumen of a neighbouring acinus. | 558.13 kB | JPEG |  View/Open |
| P_O_pancreas_vGieson_100x_50_acini_islet.jpg | Endocrine cells in the pancreatic islets, and acinar cells. No labelling. | 532.44 kB | JPEG |  View/Open |
| P_O_pancreas_vGieson_100x_46_islet_LETTERS.jpg | Detail of a pancreatic islet in a rat. Cell nuclei (Nˬi) exhibit a finely granular chromatin. The cytoplasm appears vacuolated, with small secretory granules poorly defined and some larger granules (stars). Next to the islet, vividly stained pancreatic acini (asterisks) are observed. Inset: Enhanced contrast in a capture of two islet cells. Small granules can be distinguished in the cytoplasm. Paraffin section, van Gieson trichrome. Nˬa, nuclei of acinar cells. | 513.89 kB | JPEG |  View/Open |
| P_O_pancreas_vGieson_100x_46_islet.jpg | Detail of a pancreatic islet in a rat. No labelling. | 490.32 kB | JPEG |  View/Open |
| P_O_pancreas_vGieson_100x_48_islet.jpg | Pancreatic – Langerhans – islet in a rat pancreas. The diaphragm was closed to increase the depth of focus. A cloud of cell nuclei can be readily distinguished in this islet. A finely granulated chromatin is observed in these nuclei. The cytoplasm is moderately stained – pink –, and some granulation is barely perceptible. Paraffin section, van Gieson trichrome. | 536.72 kB | JPEG |  View/Open |
| P_O_duodenum2_semithin2um_2x_01_02_collage_LETTERS.jpg | Duodenum and the adjoining pancreas in a rat. This transverse section of the duodenum shows the mucosa projecting inwards, forming the villi (black arrowheads), and the muscularis externa (me) as an outer envelope. In the mesenterium attached to the duodenum, adipose masses, blood vessels, and pancreatic lobules can be observed. Adipocytes appear solid black due to osmium tetroxide postfixation. The pancreatic lobules are darkly stained (the acini) and divided by numerous septa of loose connective tissue that are virtually unstained. Two pancreatic islets are just perceptible, stained paler than the acini. Epoxy section 2 µm thick, toluidine blue stain. ve, vein. | 578.85 kB | JPEG |  View/Open |
| P_O_duodenum2_semithin2um_2x_01_02_collage.jpg | Duodenum and the adjoining pancreas in a rat. No labelling. | 543.24 kB | JPEG |  View/Open |
| P_O_duodenum2_semithin2um_4x_05_08_09_collage_pancreas_LETTERS.jpg | Two pancreatic lobes attached to the rat duodenum. At the top, a portion of the duodenum shows the intestinal villi (black arrowheads) containing a light lamina propria (lp). A thick muscularis externa (me) is found in outer parts of the wall. In the mesenterium attached to this wall, an accumulation of adipocytes is observed: each cell contains a large lipid droplet stained solid black due to osmium tetroxide postfixation. Two pancreatic lobes are observed, containing small acini stained dark blue and paler endocrine islets. Due to a technical artefact, some acini exhibit tiny cracks and perforations. Various arteries (ar) and veins (ve) are accommodated in these tissues. Osmium tetroxide postfixation, epoxy section 2 µm thick, toluidine blue stain. | 1.04 MB | JPEG |  View/Open |
| P_O_duodenum2_semithin2um_4x_05_08_09_collage_pancreas.jpg | Two pancreatic lobules attached to the rat duodenum. No labelling. | 994.34 kB | JPEG |  View/Open |
| P_pancreas_semithin_2um_40x_02_LETTERS.jpg | Acini in a pancreatic lobule in a rat. Secretory cells exhibit a pale nucleus (N) located basally (at the periphery of the acini) and dark blue secretory granules (gr) located apically, towards the narrow lumen (L) in the centre of the acini. Numerous capillaries (c) irrigate the gland, and the nuclei of endothelial cells (black arrowheads) emerge from the thin wall. Osmium tetroxide postfixation, epoxy section 2 µm thick, toluidine blue stain. | 387.61 kB | JPEG |  View/Open |
| P_pancreas_semithin_2um_40x_02.jpg | Acini in a pancreatic lobule in a rat. No labelling. | 371.71 kB | JPEG |  View/Open |
| P_O_duodenum2_semithin2um_100X_49_acini_LETTERS.jpg | Detail of the pancreatic acini in a rat. Secretory cells are large, with a pale nucleus (N) and a bluish-grey cytoplasm in which small secretory granules (gr) stained vivid blue are observed. Secretory granules are located apically, close to the narrow lumen (empty arrowhead) of the acini. Between the acini, bands of loose connective tissue – virtually unstained – accommodate numerous capillaries with prominent endothelial cell nuclei (en) in their walls. Osmium tetroxide postfixation, epoxy section 2 µm thick, toluidine blue stain. | 474.22 kB | JPEG |  View/Open |
| P_O_duodenum2_semithin2um_100X_49_acini.jpg | Detail of the pancreatic acini in a rat. No labelling. | 455.6 kB | JPEG |  View/Open |
| P_pancreas_semithin_2um_40x_07_LETTERS.jpg | Pancreatic acini and the associated connective tissue. The exocrine acini contain large cells with a pale nucleus and small secretory granules (gr) stained vivid blue. Between the acini, loose connective tissue is present, which is virtually unstained except for a few, delicate collagen fibres (empty arrowhead) and the blood vessels. Among these, arterioles (ar), larger venules (ve), and capillaries (c and dashed bidirectional arrow segment) can be seen. Osmium tetroxide postfixation, epoxy section 2 µm thick, toluidine blue stain. | 465.11 kB | JPEG |  View/Open |
| P_pancreas_semithin_2um_40x_07.jpg | Pancreatic acini and the associated connective tissue. No labelling. | 442.3 kB | JPEG |  View/Open |
| P_O_duodenum2_semithin2um_50X_48_acini_LETTERS.jpg | Pancreatic acini next to blood vessels in a rat. The lumen of the acini (L) is narrow and the vivid blue secretory granules are located close to it, in the apical part of the cells. The nucleus (N) is located at the base of these cells – at the periphery of the acinus. Close to the nucleus, black dots are observed, likely to be small lipid droplets (li). In the connective tissue around the acini, blood vessels are observed: capillaries (c) – small and with prominent endothelial cell nuclei (en) in their walls – and larger vessels. The vessel in the upper right corner (v) is likely to be a venule, with endothelial cells in its wall and what appears to be a smooth muscle cell (sm). Osmium tetroxide postfixation, epoxy section 2 µm thick, toluidine blue stain. | 530.92 kB | JPEG |  View/Open |
| P_O_duodenum2_semithin2um_50X_48_acini.jpg | Pancreatic acini next to blood vessels in a rat. No labelling. | 497.63 kB | JPEG |  View/Open |
| P_O_duodenum2_semithin2um_100X_50_acini_LETTERS.jpg | Acinar cells and blood vessels in the rat pancreas. Secretory cells in the acini have a pale nucleus (N) located at the basal pole of the cell. These nuclei show faintly stained chromatin clumps – probably nucleoli – that are barely perceptible (empty arrowheads). In this basal region, the observed black and round deposits probably reveal small lipid droplets (li). In the apical half of the cytoplasm, small secretory granules (gr) accumulate and stain bright blue. In the unstained connective tissue, various blood vessels are seen: an arteriole (ar) with a round profile and a wall containing endothelial cells (en) and a ring of smooth muscle cells (sm); a venule with a thin wall; and a small blood vessel (v) that could be a small venule or a capillary. Osmium tetroxide postfixation, epoxy section 2 µm thick, toluidine blue stain. | 589.96 kB | JPEG |  View/Open |
| P_O_duodenum2_semithin2um_100X_50_acini.jpg | Acinar cells and blood vessels in the rat pancreas. No labelling. | 560.52 kB | JPEG |  View/Open |
| P_O_duodenum2_semithin2um_50X_58_vessels_LETTERS.jpg | Artery and vein in the rat pancreas. Blood vessels lie in the connective tissue between the pancreatic acini. Collagen fibres are thin and palely stained (empty arrowheads). The artery (ar) has a relatively thick wall containing elastic fibres stained dark blue and forming the internal elastic lamina (iel), close to the luminal surface. The tunica media of the artery consists of these elastic fibres and a layer or ring of smooth muscle cells (sm). The venule (ve) has a larger diameter and a thinner wall. At the corners of the micrograph, acinar cells can be seen stained dark blue due to the small secretory granules (gr). Osmium tetroxide postfixation, epoxy section 2 µm thick, toluidine blue stain. N, nucleus of an acinar cell. | 569.42 kB | JPEG |  View/Open |
| P_O_duodenum2_semithin2um_50X_58_vessels.jpg | Artery and vein in the rat pancreas. No labelling. | 527.65 kB | JPEG |  View/Open |
| P_O_duodenum2_semithin2um_50X_62_vessels_LETTERS.jpg | Interlobular connective tissue, vessels, and acini in the rat pancreas. In the loose connective tissue between the acini, fibroblasts (fi) and thin collagen fibres (empty arrowheads) are observed. A small artery (arˬ1), a smaller arteriole (arˬ2), a vein (ve), a smaller venule (v) and capillaries (c) can be seen. The artery exhibits a tunica media containing the internal elastic lamina (iel) stained dark blue and a thin layer of smooth muscle cells (sm). The wall of the arteriole is thinner, and even thinner in the vein. Secretory acini lie on both sides of the connective tissue. The acini present large amounts of dark secretory granules (gr) in the core, and pale nuclei (N) in the periphery – the basal pole of these cells –. Osmium tetroxide postfixation, epoxy section 2 µm thick, toluidine blue stain. | 681.93 kB | JPEG |  View/Open |
| P_O_duodenum2_semithin2um_50X_62_vessels.jpg | Interlobular connective tissue, vessels, and acini in the rat pancreas. | 638.29 kB | JPEG |  View/Open |
| P_O_duodenum2_semithin2um_100X_57_vessel_LETTERS.jpg | Artery and vein in the rat pancreas. The artery (ar) has a thicker wall, including a tunica media with a band of elastic fibres – the internal elastic lamina (iel) – and a few layers of smooth muscle cells (sm) with elongated oval nuclei (Nˬm). The vein (ve) has a thinner wall, including sparse elastic fibres (ef). These vessels are surrounded by a loose connective tissue with sparse cells – fibroblasts (fi) – and delicate collagen fibres (empty arrowheads). Next to these vessels, a triangle-shaped profile (asterisk) could correspond to a venule – like the one underneath (v) – or a lymph vessel. A pancreatic acinus can be seen at the bottom right. The cell nuclei (Nˬa) are located at the periphery, and the dark blue secretory granules (gr) are grouped in the centre, towards the narrow lumen (L). Osmium tetroxide postfixation, epoxy section 2 µm thick, toluidine blue stain. | 666.32 kB | JPEG |  View/Open |
| P_O_duodenum2_semithin2um_100X_57_vessel.jpg | Artery and vein in the rat pancreas. No labelling. | 612.28 kB | JPEG |  View/Open |
| P_O_duodenum2_semithin2um_100X_56_vessels_LETTERS.jpg | Detail of blood vessels in the rat pancreas. A small artery (arˬ1) and a smaller arteriole (arˬ2) are depicted. Both have a relatively thick wall containing smooth muscle cells (sm) with elongated nuclei (Nˬm). In the artery, the inner elastic lamina (iel) is present, and their fibres are darkly stained. The wall of the vein is much thinner and surrounded by collagen fibres (empty arrowheads). In the connective tissue, cells are scattered, including fibroblasts (fi) and plasma cells (pl). A portion of an acinus is shown in the lower right corner of the figure. Acinar cells have a pale round nucleus (Nˬa) and dark blue secretory granules (gr). Osmium tetroxide postfixation, epoxy section 2 µm thick, toluidine blue stain. c, capillary; en, nucleus of endothelial cells lining the vessels. | 546.3 kB | JPEG |  View/Open |
| P_O_duodenum2_semithin2um_100X_56_vessels.jpg | Detail of blood vessels in the rat pancreas. No labelling. | 475.02 kB | JPEG |  View/Open |
| P_pancreas_semithin_2um_conducte_40x_11_LETTERS.jpg | Small secretory duct in the rat pancreas. The duct (d) has a pale lumen which is lined with a single-layered epithelium that has cells with rounded nuclei (black arrows). These features correspond to a simple cuboidal epithelium. Cells in the pancreatic acini exhibit a pale, large nucleus (N) and numerous secretory granules (gr) stained vivid blue, which encircle the lumen of the acini (L). Osmium tetroxide postfixation, epoxy section 2 µm thick, toluidine blue stain. c, capillary. | 448.86 kB | JPEG |  View/Open |
| P_pancreas_semithin_2um_conducte_40x_11.jpg | Small secretory duct in the rat pancreas. No labelling. | 413.3 kB | JPEG |  View/Open |
| P_pancreas_semithin_2um_conducte_40x_10_10b_collage2_LETTERS.jpg | Pancreatic duct surrounded by secretory acini in a rat. The acini contain cells with a pale, large nucleus (N) and a cytoplasm filled with secretory granules (gr) – small and stained vivid blue –. A loose connective tissue (empty arrowheads), which is virtually unstained, is located between the acini and accommodates capillaries (c), larger blood vessels (v) – probably venules – and a secretory duct. The lumen of the duct (d) is filled with secretory material stained pale blue. The duct is lined with a simple epithelium containing cells with a round nucleus (black arrows). Osmium tetroxide postfixation, epoxy section 2 µm thick, toluidine blue stain. | 329.14 kB | JPEG |  View/Open |
| P_pancreas_semithin_2um_conducte_40x_10_10b_collage2.jpg | Pancreatic duct surrounded by secretory acini in a rat. No labelling. | 309.71 kB | JPEG |  View/Open |
| P_O_duodenum2_semithin2um_100X_55_61_combined_LETTERS.jpg | Secretory ducts in the rat pancreas. The lumen of the duct stains pale blue, suggesting the presence of secreted material. The duct is lined with a single-layered epithelium with large, round cell nuclei (Nˬd). The ducts are surrounded by loose connective tissue containing a number of cells, like fibroblasts (fi), spread in a pale matrix with thin collagen fibres (empty arrowheads). Next to the ducts, acini can be seen exhibiting their characteristic features: a pale, round nucleus (Nˬa) and a cytoplasm loaded with tiny secretory granules stained dark blue. bidirectional arrow, capillary in longitudinal section; c, capillary; v, blood vessel. | 1.22 MB | JPEG |  View/Open |
| P_O_duodenum2_semithin2um_100X_55_61_combined.jpg | Secretory ducts in the rat pancreas. No labelling. | 1.15 MB | JPEG |  View/Open |
| P_O_duodenum2_semithin2um_20X_37_pancreas_LETTERS.jpg | Pancreatic islet and acini in a rat. In the islet (dashed profile), endocrine cells show a pale, greyish-blue cytoplasm and paler nuclei. Some unstained spaces can be identified as the lumen of blood vessels (v). Around the islet, heavily stained pancreatic acini are observed, embedded in lightly stained connective tissue in which arterioles (a), venules, larger veins (ve), and secretory ducts (d) are located. Due to a technical artefact, some acini exhibit tiny cracks and perforations. Two tiny artefacts (X) are also seen in the islet. Osmium tetraoxide postfixation, epoxy section 2 µm thick, toluidine blue stain. | 850.9 kB | JPEG |  View/Open |
| P_O_duodenum2_semithin2um_20X_37_pancreas.jpg | Pancreatic islet and acini in a rat. No labelling. | 805.66 kB | JPEG |  View/Open |
| P_pancreas_semithin_2um_16x_03_LETTERS.jpg | Pancreatic islet and neighbouring acini in a rat. The islet appears as an oval mass of cells with poorly stained nuclei (N) and a pale bluish cytoplasm. Numerous blood vessels (v), some of which likely are capillaries, are seen in the islet and around it. The islet is surrounded by acini that show a dark blue core (asterisks) and pale nuclei located in the periphery (Nˬa). Osmium tetraoxide postfixation, epoxy section 2 µm thick, toluidine blue stain. Empty arrowhead, unstained loose connective tissue; d, secretory duct. | 572.22 kB | JPEG |  View/Open |
| P_pancreas_semithin_2um_16x_03.jpg | Pancreatic islet and neighbouring acini in a rat. No labelling. | 548.03 kB | JPEG |  View/Open |
| P_pancreas_semithin_2um_40x_06_LETTERS.jpg | Pancreatic islet and surrounding acini in a rat. Endocrine cells exhibit a pale nucleus (N) and moderately bluish cytoplasm. Some regions around capillaries (c) appear virtually unstained (star). The border of the islet is defined by the neighbouring acini, which show a heavily stained core with dark blue secretory granules (gr) and pale nuclei in the periphery. The narrow acinar lumen (L) can be observed. Osmium tetraoxide postfixation, epoxy section 2 µm thick, toluidine blue stain. | 525.04 kB | JPEG |  View/Open |
| P_pancreas_semithin_2um_40x_06.jpg | Pancreatic islet and surrounding acini in a rat. No labelling. | 505.79 kB | JPEG |  View/Open |
| P_pancreas_semithin_2um_40x_04_LETTERS.jpg | Pancreatic islet in a rat. Endocrine cells exhibit a pale nucleus (N), in which occasionally a faintly stained nucleolus (empty arrowheads) is barely perceptible. The cytoplasm is stained moderately bluish. Some regions around capillaries (c) appear virtually unstained (star). The border of the islet is defined by an acinus, which shows a heavily stained core with dark blue secretory granules (gr) and pale nuclei in the periphery. Osmium tetraoxide postfixation, epoxy section 2 µm thick, toluidine blue stain. | 472.62 kB | JPEG |  View/Open |
| P_pancreas_semithin_2um_40x_04.jpg | Pancreatic islet in a rat. No labelling. | 456.71 kB | JPEG |  View/Open |
| P_O_duodenum2_semithin2um_50X_59_islets_LETTERS.jpg | Detail of a pancreatic islet in a rat. Endocrine cells show a pale, round nucleus (N), and in some cells a slightly darker nucleolus appears to be visible (empty arrowheads). The cytoplasm stains pale blue, although some lightly stained, vacuolated regions (black arrows) are seen close to some capillaries (c). Surrounding the islet, portions of acini are depicted, characterised by dark blue secretory granules (gr). Osmium tetraoxide postfixation, epoxy section 2 µm thick, toluidine blue stain. | 711.58 kB | JPEG |  View/Open |
| P_O_duodenum2_semithin2um_50X_59_islets.jpg | Detail of a pancreatic islet in a rat. No labelling. | 686.44 kB | JPEG |  View/Open |
| P_O_duodenum2_semithin2um_100X_53_LETTERS.jpg | Secretory cells in the pancreatic islets of a rat. The predominant cells have a bluish cytoplasm with even staining and a pale nucleus (N) in which a faintly stained nucleolus is sometimes visible (empty arrowheads). These cells are likely to be the insulin-secreting β cells. Close to the capillaries (c), pale vacuolated areas (black arrows) are seen that could correspond to glucagon-containing granules of the α cells. Although they might resemble lipid droplets, this can be ruled out because such droplets would stain solid black with osmium. Osmium tetraoxide postfixation, epoxy section 2 µm thick, toluidine blue stain. | 616.35 kB | JPEG |  View/Open |
| P_O_duodenum2_semithin2um_100X_53.jpg | Secretory cells in the pancreatic islets of a rat. No labelling. | 589.64 kB | JPEG |  View/Open |
This item is licensed under a
Creative Commons License



